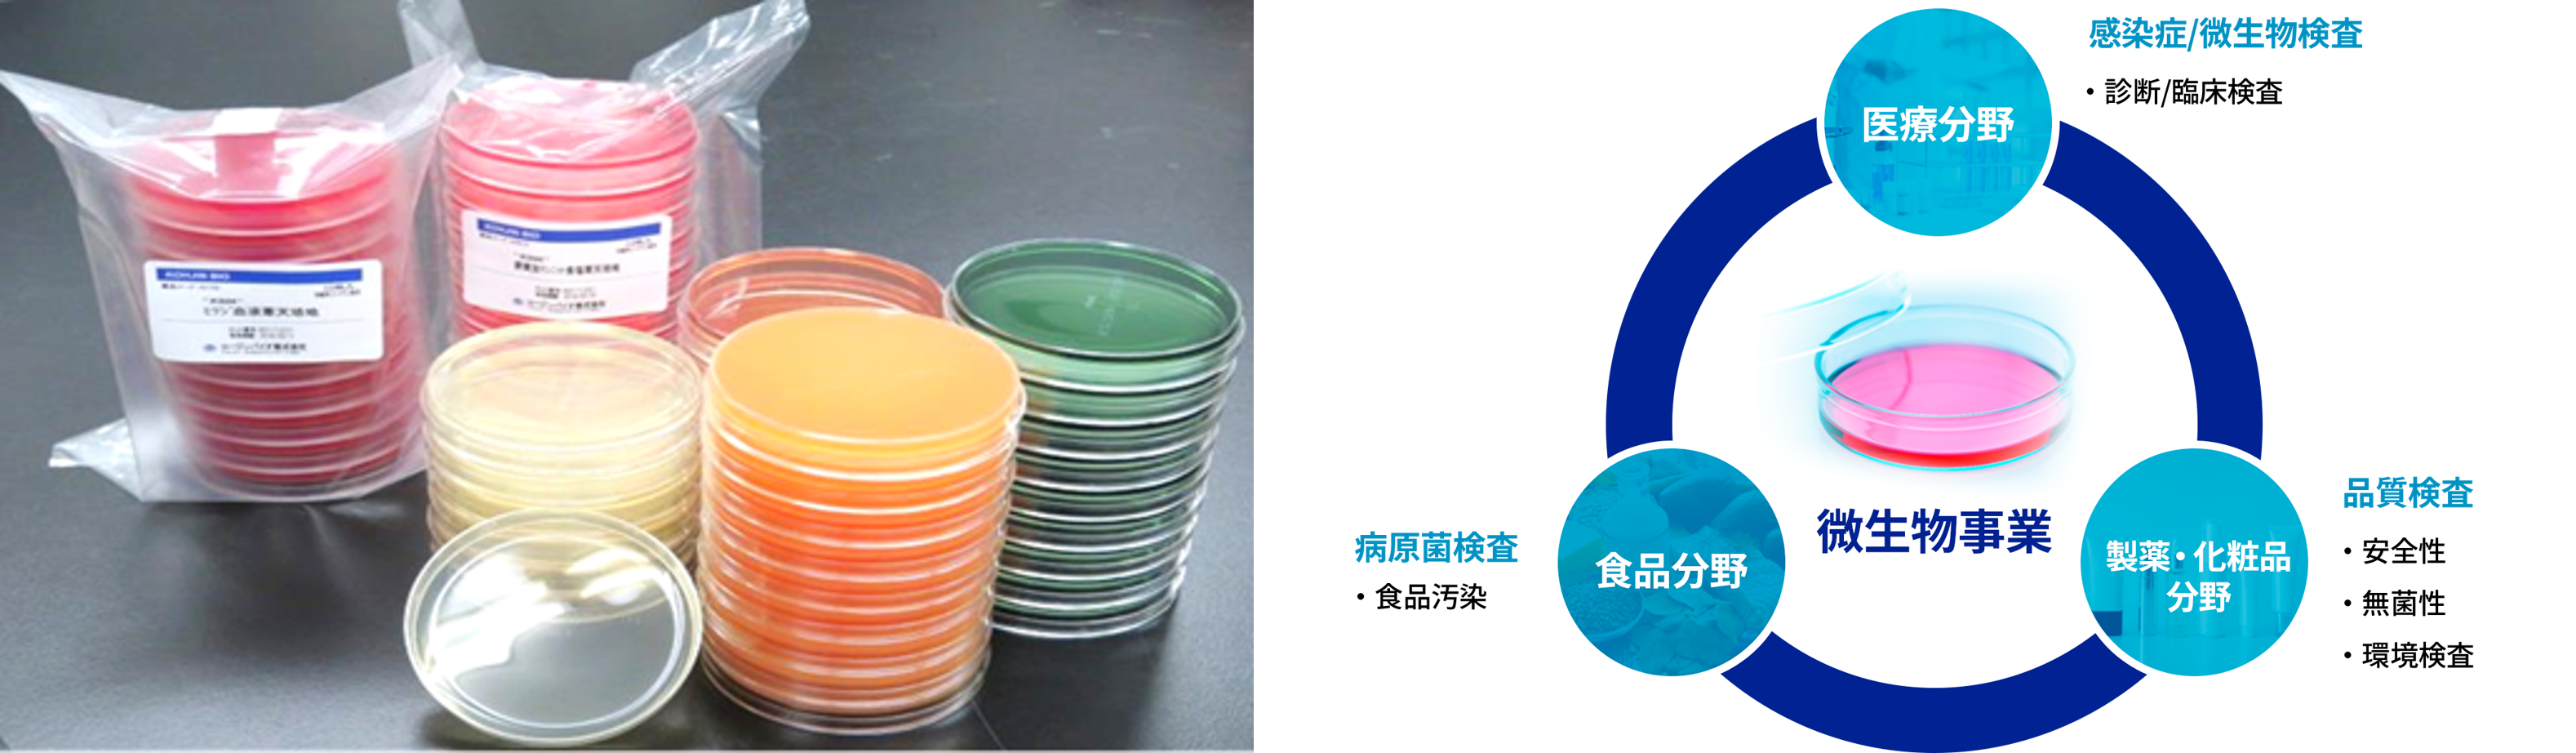

お気に入り登録を解除しますか?
ライフサイエンス企業情報プラットフォーム
コージンバイオ株式会社
再生医療や免疫療法の研究で使用される組織培養用培地、臨床・食品分野の病原菌検査などの品質検査に使用される微生物検査製品、および培養関連機器
会社カテゴリー:その他受託サービス、再生医療関連、医薬品製造関連資材
主サービス提供地域:日本
会社概要
| 会社名 | コージンバイオ株式会社 |
|---|---|
| 所在地 | 埼玉県坂戸市千代田5丁目1番地3 |
| 電話番号 | 049-284-3781(代表) |
| ホームページ | https://kohjin-bio.jp/ |
| 設立 | 1981年(昭和56年)4月20日 |
| 資本金 | 12億5398万4400円 |
事業内容
コージンバイオ株式会社では、再生医療や免疫療法の研究で使用される細胞培養用培地の開発や製造・販売(組織培養事業)、臨床・食品分野の細菌検査などの品質検査に使用される微生物検査製品の提供(微生物事業)、特定細胞加工物の製造(細胞加工事業)を行っております。
組織培養培地事業
再生医療や免疫療法の研究用途で使用される無血清培地をはじめとする組織培養用培地を開発、製造・販売しております。
長年の経験と実績や、PMDAの材料適格性相談などを有効に活用することで、すべての培地を生物由来原料基準に適合した形で生産できる体制を整えております。

感染症微生物事業
臨床・食品分野の病原菌検査や、様々な分野の品質検査に使用される微生物検査用培地をはじめ、微生物検査に関わる製品の開発、製造・販売を行なっています。
当社の製品は病院や製薬会社、検査センター等で使われることが多く、国内外の保健医療に貢献しています。
再生医療細胞加工事業
再生医療等安全性確保法に基づき特定細胞加工物製造の許可を取得した施設において、医療機関からの細胞加工受託の事業を行っております。
主に免疫療法、幹細胞治療を行う医療機関からのご依頼に基づき、臨床培養士の管理監督の元、特定細胞加工物の製造を行っております。

企業メッセージ
『品質第一主義』での製品製造を心がけ、バイオテクノロジーの発展に貢献
コージンバイオ株式会社は、1981年にコージン株式会社としてスタートを切りました。
会社名の『コージン』は考える人(考人)の組織集団であるというコンセプトで、バイオテクノロジーの技術をビジネスとしてどう産業に活かすかを日々探究しております。
多種多様な製品を安定供給し構築したコージンバイオブランド

ニュースリリース
現在、該当する情報がありません。
ニュースリリース
現在、該当する情報がありません。
-
<%=SectionNews%>
製品・サービス
サービスカテゴリー検索
サービスサブカテゴリ―
キーワード検索
現在、該当する情報がありません。
<%=SectionService%>
キャンペーン
現在、該当する情報がありません。
<%=SectionCampaign%>
セミナー
現在、該当する情報がありません。
<%=SectionSeminar%>
ホワイトペーパー
現在、該当する情報がありません。
<%=SectionWhite%>